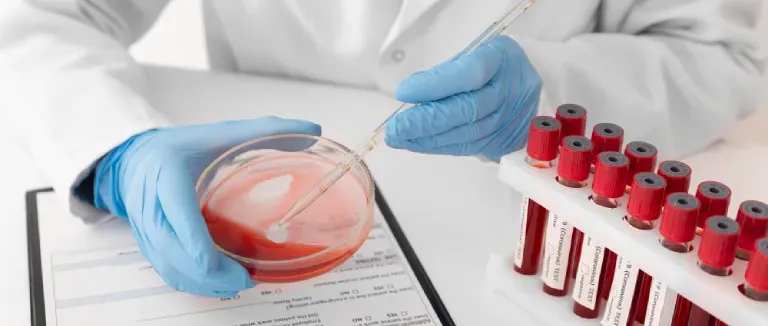
alt yüksekliği nedir?

Alt Yüksekliği Nedir?
- ALT (Alanin Transaminaz) Nedir?
- Alanin Aminotransferazın (ALT) Aspartat Aminotransferazdan (AST) Farkı Nedir?
- Alanin Transaminaz (ALT) Kan Testi Nedir?
- Neden ALT Kan Testine İhtiyaç Vardır?
- ALT Yüksekliği Belirtileri
- Alanin Aminotransferaz (ALT) Yüksekliği Neden olur?
- Alanin Aminotransferaz (ALT) Tedavisi Nasıl Yapılır?
- Alt Yüksekliği Hakkında Sık Sorulan Sorular
Son Güncelleme Tarihi 26.01.2026 09:06:42
Alanin transaminaz enzimi yaş, cinsiyet, egzersiz ve diyet durumuna göre farklı sonuçlar verebilir. Bu yüzden farklı çıkan her ALT sonucunda endişelenmeden süreç takip edilmelidir. Yüksek olarak çıkan her ALT değeri endişe yaratmadığı gibi bazen de enfeksiyon, siroz, hepatit gibi hastalıklardan kaynaklandığı da görülmüştür. ALT yüksekliği karaciğerde oluşan hasar ile ilgili bilgi vermez ama bireyi alarma geçirir. ALT enzimi olması gerekenden yüksek çıktığında bireyler karaciğer fonksiyon testlerini yaptırmaları için yönlendirilir.
Aspartat aminotransferaz ya da aspartat transferaz olarak bilinen AST enzimi karaciğer, kalp, beyin, böbrekler, pankreas, kaslarda ve vücudun birçok dokusunda bulunur. Fakat birçok yerde bulunsa da en yaygın ilişkisi karaciğerledir. Karaciğer fonksiyon testleri birlikte yorumlanmalıdır. Alkalen fosfataz seviyesi de bu değerlendirmede dikkate alınan göstergeler arasında yer alır.
AST değeri testlerde yüksek çıktığında kaslarda, karaciğerde, kalpte ve böbrekte bir hastalık olduğunu ifade eder. Aspartat transaminaz enziminin yükselmesine neden olan hastalıklarda siroz, kronik hepatit, safra kanallarının tıkalı olması, karaciğer kanseri olabilir. Karaciğerde yağlanma, nöromüsküler hastalıklar, anjiyoplasti ve güneş çarpması, gebelik gibi durumlar da AST değerinin yükselmesine neden olabilir.
ALT, AST yüksekliği bireyleri alarma geçiren değerlerdir. Test sonuçlarında bu durumla karşılaşıldığında öncelikle karaciğer ile ilgili testlerin yapılması önerilir.

ALT (Alanin Transaminaz) Nedir?
Alanin transaminaz olarak adlandırılan ALT enzimi alanin aminotransferaz olarak da bilinir. Vücudun farklı bölgelerinde de bulunun alanin transaminaz enzimi esas olarak karaciğerde sentezlenir. Alanin transaminaz enzimi bir hücrede katalizör görevi görür. Bazı bedensel süreçlerin gerçekleşmesinde rolü olan bir tür protein çeşididir. İnsan vücudunda farklı görevlere sahip binlerce enzim çeşidinden biridir ve pek çok görev üstlenir.
Alanin Aminotransferazın (ALT) Aspartat Aminotransferazdan (AST) Farkı Nedir?
Aspartat transferaz (AST) enzimi karaciğerde ve metabolik alanda alanin transferaz (ALT) ile birlikte yaygın olarak görülen enzimlerdir. Her iki enzimde vücutta bazı bölgeler hasar gördüğünde kan dolaşımına sızabilirler.
Her iki enzim de karaciğer enzimi olarak kabul edilse de AST enzimi kalp, iskelet kasları, pankreas gibi vücudun diğer bölgelerinde daha fazla bulunur. Bundan dolayıdır ki ALT değeri daha karaciğere bağlı bir değermiş gibi görünür. Fakat karaciğer sağlığı değerlendirilirken her iki değerde göz önünde bulundurulur.
Alanin Transaminaz (ALT) Kan Testi Nedir?
Alanin aminotransferaz kan testinde kanınızdaki ALT değerini ölçer. Karaciğer hasar gördüğü zaman kandaki ALT seviyeleri artabilir. Artan ya da azalan ALT değerinin kontrolü için belli aralıklara bu testler doktorlar tarafından istenir.
Birçok karaciğer hasarı alanin transaminaz seviyesinin yükselmesine neden olabileceğinden sağlık uzmanları bu testi tek başına istemezler. Genellikle karaciğer enzim paneli (HFT ya da LFT) veya kapsamlı bir metabolik panel (CMP) gibi kan testi paneline eklenir. Kan paneli alınan bir numune ile kandaki çeşitli değerleri ölçer ve sağlığınız hakkında bilgi verir.
Alanin transferaz kan testinin yaygın adları aşağıda verildiği gibidir.
- Alanin transaminaz: ALT enzimi olarak bilinir.
- Alanin aminotransferaz: ALT enzimi olarak bilinir.
- Serum Glutamik Pirüvik Transaminaz (SGPT): Alanin aminotransferaz enzimi SGPT olarak bilinen bir enzimdir.
- Gama Glutamil Transferaz (GGT): Gama glutamil transferaz enzimi vücutta çoğunlukla da karaciğer de bulunan bir enzimdir. Karaciğer hasar gördüğünde kana sızabilir ve kanda GGT yükselmesi ile fark edilir.
Neden ALT Kan Testine İhtiyaç Vardır?
ALT kan testinin yapılmasındaki amaç karaciğer sağlığını kontrol etmektir. Karaciğerdeki hücreler zarar gördüğü zaman ALT enzimi kana sızar ve kanda ALT yüksekliği ile karşılaşılır. Albumin seviyesi de bu değerlendirmede önemli parametrelerden biridir.
ALT Yüksekliği Belirtileri
ALT yüksekliği (alanin aminotransferaz) karaciğer için bir alarm bulgusudur. Diyabet, hepatit, obezite, tansiyon, karaciğer yağlanması gibi hastalıklarla ALT değeri yükselebilir. Bu durum takip ve tedavi gerektirir.
Alanin transaminaz enzimi her zaman belirti vermeyebilir. Ancak karaciğerde oluşan hasar nedeniyle aşağıdaki belirtiler ortaya çıkabilir.
- Koyu renkli idrar
- Mide ağrısı
- Kaşıntı
- Sarılık (Cilt ve gözlerde sararma)
- Halsizlik
- İştahsızlık
- Mide bulantısı, kusma
- Açık renkli dışkı
- Hızlı kilo kaybı, kaşektik görünüm
Bu belirtilerin birkaçı en az altı hafta bir kişide bulunması hepatoselüler hasarın oluştuğu ile ilgili bulgulardır. Bu belirtileriniz var ise hemen doktora başvurmalısınız.
Alanin Aminotransferaz (ALT) Yüksekliği Neden olur?
Alanin aminotransferaz değerini etkileyen birçok etken vardır. Bu etkenler cinsiyet, yaş gibi değiştirilemez etkenler olabileceği gibi çevresel faktörlerden kaynaklı da olabilir. Genetik olarak kişilerde bulunan hastalıklara ek olarak sonradan ortaya çıkan karaciğer hastalıklarına kadar geniş bir alanda değerlendirilir. Bundan sebeptir ki yapılan testler hastaya ve hastalığa özgüdür. ALT yüksekliği görülen hastalarda aşağıdaki hastalıklar bulunabilir:
- İlaç reaksiyonları ve ilaç toksisitesi
- Wilson hastalığı
- Otoimmün hepatit
- Akut viral hepatit
- İskemik hepatit
- Sitomegalovirüs (CMV)
- Parsiyel hepatektomi
- Kas hastalıkları
- Zehirlenme
- Sıcak çarpması
- Çölyak hastalığı
- Anoreksiya nervoza
- Tiroid bozuklukları
- Kalp hastalıkları
- Obezite
- Epstein-Barr virüsü (EBV)
Kronik karaciğer hastalıklarında orta ya da hafif yükselmeler olabilir. Meydana gelen hafif ve orta karaciğer hasarlarında geçici ALT değeri yükseklikleri daha fazla meydana gelir. Hepatitin herhangi bir çeşidi kendisinde veya ailesinde bulunanlar, karaciğeri etkileyen ilaç kullanımı olanlar, fazla kilolu kişiler, diyabet tanısı almış bireyler ALT değerlerini düzenli olarak kontrol ettirmelidirler.
Alanin Aminotransferaz (ALT) Tedavisi Nasıl Yapılır?
Yükselen alanin aminotransferaz değerini düşürmek için direkt olarak uygulanan bir tedavi yöntemi yoktur. Yükselen ALT değerinin tedavi seçenekleri nedene yöneliktir. Bu yüzden tedavi için ilk önce alanin transaminaz neden yükseldiği tespit edilmelidir.
ALT yükselmesi önemli bir bulgu olarak kabul edilir. Bu sebepten referans aralığından küçük olarak meydana gelen yükselmelerde değerlendirilir. ALT değeri üst sınırından çok fazlasına yükseldiğinde hemen tedavi gerekir. Genelde viral hepatitlerde ALT değerinde çok fazla yükselme görülür. Altı aydan uzun süren yüksekliklerde kronik karaciğer hastalıklarını ifade eder.
ALT değerindeki yükselmeler vücuda giren toksin, zararlı madde, zehir ya da ihtiyaçtan fazla alınan besin anlamına gelebilir. Bu nedenle olan hastalıkların yanında yanlış ve fazla beslenme, yetersiz besin alımı, kas hastalıkları, diyabet bu enzimin anormal olarak yükselişini açıklayabilir. Alanin aminotransferaz (ALT) değerini düşürmek için hem farmakolojik tedavi hem de hastanın aşağıda verilenler gibi yaşam değişikliklerini tercih etmesi gerekir.
- Folik asit takviyesi almak
- Yeterli ve dengeli beslenmek (diyetisyen önerisi alınabilir)
- Egzersiz yapmak (yürüyüş, spor)
- Fazla kilolardan kurtulmak
- Kahve tüketimini artırmak
- Düşük kolesterollü yiyecekler ile beslenmek
- Hepatit aşılarını zamanında yaptırmak
Alanin aminotransferaz (ALT) değerini yaşam tarzı değişikliği ile düzenlemek alınan farmakolojik tedaviye göre daha etkili sonuçlar verebilir. Yukarıda verilen yaşam tarzına uyarak ALT değerini referans aralığına indirmek mümkündür. Fakat ciddi ALT değeri yüksekliklerinde hastanın farklı hastalık şüphesi varsa tetkikler daha geniş çaplı yapılabilir. Kan testlerinin yanında karaciğer ultrason görüntüsü, biyopsi, abdominal tomografi, kreatin kinaz testi, demir ölçümü ve lipid paneli yapılabilecek diğer tetkiklerdendir.
Alt Yüksekliği Hakkında Sık Sorulan Sorular
Karaciğer enzimleri vücutta farklı enzimlere bağlı olarak da artış gösterdiği için bireyler testlerinde yüksek çıkan değerleri araştırma gereği hissederler. Aşağıda sıklıkla aranan sorular değerlendirilmiştir.
ALT AST Yüksekliği Neden Olur?
ALT AST değeri yükselmesinde ilk önce akla gelen karaciğer de hasar olduğudur. ALT AST yüksekliği ile karşılaşıldığında farklı karaciğer fonksiyon testleri de yapılır. Aşağıda bu değerleri yükselmesine neden olabilecek bazı hastalıklar verilmiştir.
- Alkolün neden olduğu karaciğer hasarı
- Karaciğer için toksik ilaçlar kullanmak
- Hepatit
- Siroz
ALT ve AST enzimleri vücudun farklı noktalarında da bulunduğu için o bölgelerde hasar oluştuğunda da bu kanda bu değerlerin yüksekliği görülebilir.
ALT, AST Yüksekliği Nasıl Düşer?
ALT AST yüksekliğinin iki çeşit tedavisi vardır. Biri farmakolojik tedavidir. Bu tedavinin planlanması için doktorlar önce altta yatan hastalık nedenini teşhis etmelidir. İkinci tedavi de ise yaşam şeklinde değişiklikler yapmak gerekmektedir. Alkol kullanımı var ise sınırlandırılmalıdır. Dengeli ve düzenli beslenmek gerekir. Şeker kullanımı, yağ kullanımı sınırlandırılmalıdır. Yaşamın içine egzersiz dahil edilmelidir.
Sonuç olarak alanin aminotransferaz enziminin yüksek olması her zaman ciddi bir sonuç değildir. ALT değerini birçok faktör etkileyebilir. Bu yüzden bu durumlarda tedbirli olunmalı, süreç gözlemlenmelidir. ALT değerindeki yükselmeye bağlı olarak doktorunuz sizi yönlendirecektir. ALT değeri çok yüksek ise veya doktorunuz farklı karaciğer tetkikleri de yaptırmanızı istiyorsa ihmal etmeden doktora başvurmalısınız.
* Web sitemizdeki içerikler sadece bilgilendirme amaçlıdır. Tanı ve tedavi için mutlaka hekiminize başvurunuz. Sayfa içeriğinde Liv Hospital'da tedavi edici sağlık hizmetine yönelik bilgiler içeren ögelere yer verilmemiştir. .